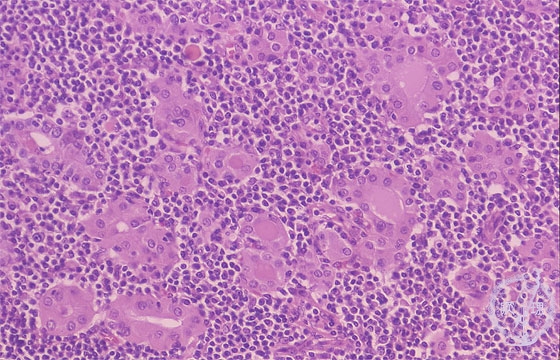

- 13.Endocrine
- ★(4)Chronic thyroiditis (Hashimoto disease)
Microscopic findings (HE stain, high power view). Marked lymphocytic infiltration in the thyroid. Thyroid follicular cells are enlarged with oxyphilic cytoplasm (arrows).
Click the image to see the enlarged image.